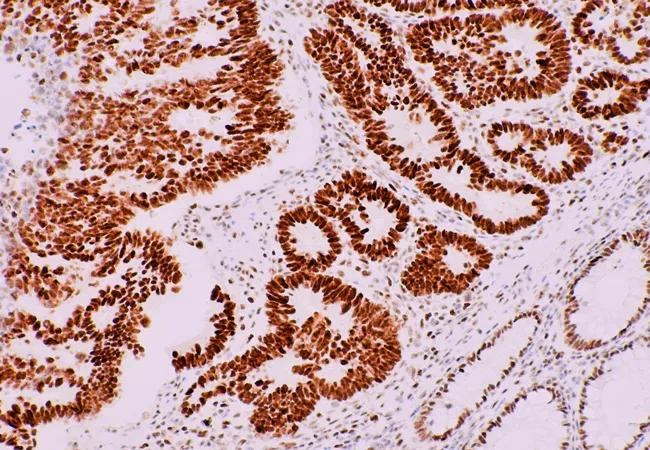

Screening patients over 70 can help identify cancer in families
Image content: This image is available to view online.
View image online (https://assets.clevelandclinic.org/transform/9e40d27e-43d3-4be8-a42b-76726ddaacfb/colon-cancer_650x450_jpg)
colon-cancer_650x450
Although guidelines recommend universal tumor screening of newly diagnosed colorectal cancer, many practitioners discontinue screening patients over age 70. A study presented at the International Society of Gastrointestinal Hereditary Tumors (InSiGHT) in San Paulo, Brazil, by Cleveland Clinic researchers showed the potential error of this practice. Screening of patients past age 70 can identify missed cases of Lynch syndrome, and this can have a profound impact on future generations in patients’ families.
Advertisement
Cleveland Clinic is a non-profit academic medical center. Advertising on our site helps support our mission. We do not endorse non-Cleveland Clinic products or services. Policy
Not counting skin cancers, colorectal cancer is the third most common cancer in the United States and more than 140,000 new cases are diagnosed each year. About 5 percent of all colorectal cancers arise within a hereditary syndrome, predisposing people carrying certain genetic mutations to cancer at a higher rate and at a much younger age than the general population.
The most common hereditary syndrome that predisposes people to colorectal and certain other cancers is Lynch syndrome, a form of Hereditary Nonpolyposis Colorectal Cancer (HNPCC). A person with Lynch syndrome has between a 52 and 82 percent lifetime risk of developing colorectal cancer, and also increased risk of developing other cancers, including uterine, ovarian, stomach, pancreas, kidney and brain. First-degree relatives of someone with Lynch syndrome (children, parents, siblings) have a 50 percent chance of carrying the defective gene.
“Many studies show that colonoscopy can prevent cancer from developing, and prevents death from cancer in certain hereditary syndromes,” says Matthew Kalady, MD, the study’s lead author and Vice Chairman of the Sanford R. Weiss, MD, Center for Hereditary Colorectal Neoplasia.. “By identifying people with a hereditary syndrome, we can intervene in meaningful ways,” he continues.
Initial universal tumor screening involves microsatellite instability (MSI) analysis looking for DNA mismatch repair deficiency, a high frequency of which is a hallmark of Lynch syndrome, and immunohistochemistry (IHC) to look for loss of expression of DNA mismatch repair (MMR) proteins. Positive tumors are then tested for germline mutations.
Advertisement
“Universal screening of colon cancers is recommended already, but not many institutions do it consistently. The Cleveland Clinic is a leader in universal tumor screening in colon cancer,” Dr. Kalady reports. “Since 2009, we’ve performed universal screening in about 5,000 cases, and we’ve identified people who would not otherwise have been picked up with Lynch syndrome.”
Identifying Lynch syndrome in patients can have tremendous implications for them and their families. For instance, surgeons can opt for more extensive surgery in a 50-year-old father diagnosed with colon cancer and identified as having Lynch syndrome, Dr. Kalady explains. The patient also would need regular screening for other cancers.
Women with Lynch syndrome need to have close surveillance for uterine and ovarian cancer because of their increased chance of developing cancer in those organs.
In addition, with their 50 percent chance of inheriting Lynch syndrome, first-degree relatives need genetic counseling and testing, and surveillance if they test positive. Screening for Lynch syndrome among relatives is recommended starting at age 20, Dr. Kalady says.
The Cleveland Clinic study involved 882 patients, ages 23 through 99, diagnosed with colorectal cancer between November 2012 and June 2014. Of these patients, 122 (13.8 percent) were shown to be mismatch repair deficient (dMMR), either by MSI or lacked MMR IHC expression, and 34 patients (3.9 percent) had suspected or confirmed Lynch syndrome based on tumor and genetic testing. Eighteen percent of confirmed Lynch syndrome patients were older than age 70.
Advertisement
“Some physicians screen only up to age 70 because they think finding Lynch syndrome after that age is rare,” says Dr. Kalady. “Our data show that if we screened only people younger than 70, we’d miss 18 percent of Lynch syndrome in our patient population. These patients already have children and probably grandchildren who are at risk and also should be screened.”
An analysis of the cost effectiveness of universal tumor screening in older patients is underway, researchers reported.
Advertisement
Advertisement
First-of-its-kind research investigates the viability of standard screening to reduce the burden of late-stage cancer diagnoses
Global R&D efforts expanding first-line and relapse therapy options for patients
Study demonstrates ability to reduce patients’ reliance on phlebotomies to stabilize hematocrit levels
A case study on the value of access to novel therapies through clinical trials
Findings highlight an association between obesity and an increased incidence of moderate-severe disease
Cleveland Clinic Cancer Institute takes multi-faceted approach to increasing clinical trial access 23456
Key learnings from DESTINY trials
Overall survival in patients treated since 2008 is nearly 20% higher than in earlier patients